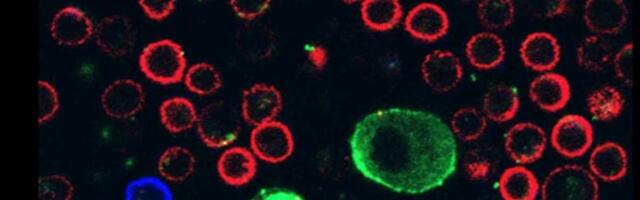
Otkrivanje mehanizma kojim ćelije melanoma parališu imunske ćelije

781 mesto 0 sveže
Napravljen je veliki korak napred sa dalekosežnim implikacijama po lečenje smrtonosnog raka kože.
Newsletter svaki dan!
Možete dobiti 10 najvažnijih vesti oko podneva u dnevnom newsletteru. Pritisnite taster i poslaćemo samo najvažnije vesti, bez spama.
LAJKUJ nas na Fejsbuku i neces propustiti najvaznije vesti dana!
Predsednik Republike Srbije Aleksandar Vučić upravo se obraća građanima Srbije. Pročitaj više ›
1,691
Povodom novogodišnjih i božićnih praznika neradni dani su 1, 2, 6, 7. i 8. januar 2026. godine, saopšteno je iz crnogorskog Ministarstva rada, zapošljavanja i. Pročitaj više ›
1,151
Stotine ljudi širom Srbije dobile su otkaze ili su premeštene na niža radna mesta zbog podrške ili učešća u protestima, ali i zbog odbijanja da idu na skupove Srpske napredne stranke. Na udaru režima su i javni i privatni sektor, pokazuje istraživanje BIRN-a. Jedna od njih je Suzana Rogan, profesorka književnostu Trgovinsko ugostiteljske škole „Toza ... Pročitaj više ›
1,125
UŽIVO VUČIĆ OTKRIO DETALJE ZA NIS: "MOL je radio zajedno s nama na dobijanju dozvole" Pročitaj više ›
1,109
Novak Đoković je čestitao svim pratiocima na Instagramu Novu 2026. godinu. Čestitku je uputio na nekoliko svetskih jezika, ostavljajući, naravno, srpski za kraj. Pročitaj više ›
1,031
Kao i prethodnih trinaest godina, i u 2025. Goran Marković se nije ni primakao mogućnosti da snima novi film uz podršku Filmskog centra Srbije, sudski spor koji vodi protiv Ministarstva kulture još nije okončan, ali je jedan od naših najznačajnijih filmskih autora sredinom leta, na radost filmofila i književne publike koja njegove knjige "čita kao da gleda njegove filmove", predstavio svoj novi roman "Hamlet u Paviljonu br. 6". Pročitaj više ›
1,014
Stravična eksplozija i požar koji su se dogodili sinoć, u novogodišnjoj noći, progutali su klub u Švajcarskoj, u liksuznom skijalištu Kran-Montana i ostavili. Pročitaj više ›
953
JEDAN SRBIN IPAK BIO U DISKOTECI SMRTI U ŠVAJCARSKOJ KAD JE IZBIO POŽAR! Od Stefana Ivanovića (31) ni traga ni glasa, porodica očajna: OVO daje nadu da je živ Pročitaj više ›
750
U Opštoj bolnici Leskovac prva beba u 2026. godini rodila se jutros u 8.30 časova, devojčica Milica od 2.650 grama i dugačka 47 centimetara a na svet je donela Miljana Denčić (2006) iz Bratmilovca, potvrđeno je Jugmedii u ovoj zdravstvenoj ustanovi. Inače, majka Miljana je prvorotka i porođaj je prošao odlično, i majka i beba su dobro. Podsetmo, na jučerašnjoj sednici Gradskog veća odobrena su novčana sredstva za prvih 100... Pročitaj više ›
733
Mlađi muškarac bacio se danas sa prozora jedne zgrade u širem centru Beograda, a nakon što je, kako nezvanično saznajemo, devojka sa kojom je bio u stanu. Pročitaj više ›
631
Jedanaestogodišnji dečak primljen je danas u bolnicu sa prostrelnom ranom na ruci, nakon incidenta koji se dogodio u okolini Barajeva pod još uvek. Pročitaj više ›
625
Osmu godinu zaredom penzioner iz Kraljeva u kostimu Deda Mraza, hladne decembarske dane provodi na ulici uveseljavajući mališane, a poslednjeg dana u godini u ponoć nosi paketiće koje sam pravi deci na odeljenje Kraljevačke bolnice. Da zaista ima super-moći, govori i podatak da sve to radi sa polomljenim rebrom, jer, kako kaže, u decembru ima ... Pročitaj više ›
475
TRAGEDIJA U CENTRU BEOGRADA Mladić skočio sa 9. sprata zgrade nakon što mu je devojka umrla pred očima: Sve nadležne službe na terenu Pročitaj više ›
463
HOROR U SURČINU U NOVOGODIŠNJOJ NOĆI Satima se iživljavao nad devojkom u stanu: Dok su drugi slavili, on je tukao, čupao, udarao joj glavu o zid... Pročitaj više ›
443
Ministar finansija Siniša Mali izjavio je za RTS da Srbija u 2026. godinu ulazi sa očuvanom makroekonomskom stabilnošću, rastom plata i penzija i nastavkom velikih investicionih projekata. Pročitaj više ›
421
Prvi potpredsednik Vlade i ministar finansija Siniša Mali izjavio je danas da će prosečna plata u 2026. godini će biti veća od hiljadu evra, dok će do kraja 2027. godine prosečna plata u Srbiji dostići 1.400 evra, a prosečna penzija i minimalna zarada po 650 evra. Kako je Mali naveo, povećane plate u javnom sektoru i minimalna zarada lepa vest za građane i da je ponosan jer je, uprkos svim... Pročitaj više ›
417
Voditeljka Jovana Jeremić, oglasila se putem Instagrama povodom loših komentara na račun njenog performansa u specijalnom novogodišnjem jutarnjem programu, pa. Pročitaj više ›
383 sveže
DEČAK (11) KOD BARAJEVA OSETIO "UBOD", A ONDA KRENULA KRV! U bolnici šokirani: Mališan ima prostrelnu ranu - pogođen dok je vozio bicikl Pročitaj više ›
381
Bivši predsednik Srbije Boris Tadić čestitao je Novu godinu i poželeo da promenu "štetočinske vlasi koja kriminalizuje Srbiju". Pročitaj više ›
366
Premijer Srbije Đuro Macut je danas ocenio kao važnu i ohrabrujuću vest to što su SAD produžile licencu za rad Naftne industrije Srbije (NIS) do 23. januara, saopštio je njegov kabinet. Pročitaj više ›
366
Pokret "Srce heroja" objavio je danas da je preminuo njihov član, saborac, kolega i drug Dalibor Bogićević Bogi, pripadnik MUP-a u penziјi. Pročitaj više ›
5,331
Prva beba u Novoj 2026.godini rođena je u GAK Višegradska u Beogradu. U pitanju je ,saopštio je odmah posle ponoći za Telegraf.rs direktor ove ustanove, prof. Pročitaj više ›
3,045
Prva beba u Novoj 2026. godini rođena je u GAK Višegradska u Beogradu. U pitanju je dečak, porodila se majka Marina Milošević. Pročitaj više ›
2,716
Predsednik Srbije Aleksandar Vučić obratio se javnosti i govorio o penzijama, ističući da će penzioneri za pet dana dobiti najveću penziju u istoriji. Pročitaj više ›
2,457
Predsednik Republike Srbije Aleksandar Vučić obratio se građanima ispred Narodne skupštine Republike Srbije, nakon čega je obišao Pionirski park. Pročitaj više ›
1,928
Prestonica je konačno odahnula nakon višečasovne drame koja je podsećala na najmračnije filmske scenarije. Pročitaj više ›
1,478
Predsednik Srbije Aleksandar Vučić rekao je, na svečanosti povodom polaganja kamena temeljca za novi Generalštab Vojske Srbije, da će se šatori iz Pionirskog. Pročitaj više ›
1,363
Predsednik Srbije Aleksandar Vučićobjavio je na X profilu čestitku građanima Srbije, uz poruku da se nada da će se u narednih 24 sata svi obrati fenomenalnim. Pročitaj više ›
1,227
Novak Đoković je na World Sport Summitu u Dubaiju istakao da su mu Olimpijske igre u Los Anđelesu 2028. godine glavni cilj, pored mogućeg osvajanja 25. Pročitaj više ›
754
Kako saznajemo, predsednik Srbije Aleksandar Vučić je upravo obavio važne razgovore sa Vašingtonom, i uskoro se očekuje objavljivanje dobre vesti za Srbiju. Pročitaj više ›
712
Najpopularniji izvori
|
|
19% 1 |
|
|
17% 5 |
|
|
11% 1 |
|
|
10% 8 |
|
|
7% 6 |
| Pogledaj izvore » | |
LAJKUJ nas na Fejsbuku i neces propustiti najvaznije vesti dana!
02.01.2026 02:03
Ažurirano: 01:47.
Pozicija vesti je ažurirana u: 02:50
Šta je Svetionik.com?
Svetionik.com ti donosi najpopularnije vesti sa srpskih news portala u tabeli u realnom vremenu.
Prijatelji sajta
Ocenjivanje slika
Upoznavanje preko Interneta
Prevoz do aerodroma
Honorarni poslovi Beograd
Pročitaj o nama u FAQ sekciji
In another language
Српски / srpski Eesti keel (Eesti uudised) Русский язык (новости Эстонии) Українська мова (новини Естонії)